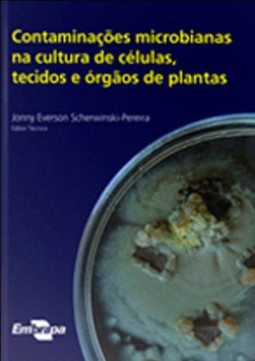

CADASTRE-SE
CONTAMINAÇÕES MICROBIANAS NA CULTURA DE CÉLULAS, TECIDOS E ÓRGÃOS DE PLANTAS
Jonny Everson Scherwinski-pereira (0) votos | (0) comentários
Sinopse
Na cultura de células, tecidos e órgãos de plantas, as contaminações causadas especialmente por fungos, bactérias, vírus e vegetal em laboratórios de pesquisa e biofábricas de produção de mudas. E, apesar dessa importância, são relativamente poucos os trabalhos que tratam do assunto, em razão do desconhecimento do tema e, notadamente, das técnicas envolvidas no processo. A publicação Contaminações microbianas na cultura de células, tecidos e órgãos de plantas atende a uma forte demanda relacionada com os processos de boas práticas de laboratório e contribui para preencher algumas lacunas encontradas na área de Biotecnologia Vegetal referentes aos problemas de contaminação in vitro. A obra busca se aprofundar em conceitos e informações oriundos da pesquisa com a finalidade de refletir o estado da arte em contaminações, proporcionando à comunidade científica uma fonte de consulta com bases teóricas e aplicações práticas sobre o tema.
| Categoria | |
| Editora | Embrapa |
| ISBN-13 | 9788573834857 |
| ISBN | 8573834854 |
| Edição | 1 / 2010 |
| Idioma | Português |
| Páginas | 448 |
| Estante | 0 0 0 0 |
| Sua estante | |
5% chance de ser solicitado
CADASTRE-SE
AVALIAÇÃO DO LEITOR
Quero comentar sobre este livro